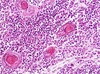

División del sistema linfoide (2)
-Nodular
-Difuso (esta desoordenado y no se puede determinar que forma tiene)
Nodular se divide en
-Capsulado
-No encapsulados
Nodulos capsulados (3)
-Ganglios linfáticos
-Timo
-Bazo
Nodulos no encapsulados
-Placas de Peyer (ileón)
E.g. de difuso
Sistema MALT (O GALT depende de donde este) malt es tejido linfoide asociado a mucosas, cualquier mucosa que tenga tejido linfoide es MALT y es difuso
Tienen centros germinales
Es la inmunidad con la que nacemos
INMUNIDAD NATURAL O INNATA
Esta inmunidad es por contacto, rápida e inespeficifica
Inminudad innata o natural
Notita de inmunidad innata o natural
-Se encuentra en las mucosa, va a ser lo primero en responder pero como no es tan específica no es tan funcional PERO va a mantener a la infección para que entre la inmunidad especifica y pueda destruir.
Va ser activa o pasiva
Esta mediada por células y proteínas que se hallan siempre presentes y equilibradas para luchar frente a los microbios y son llamdas a entrar en acción para eliminar o prevenir una infección.
-Adquirida por herencia o medios biológicos.
INMUNIDAD NATURAL O INNATA
Inmunidad innata activa
Requiere gastar energía el cuerpo humano para producirla
E.g. de inmunidad pasiva
Cuando la mamá amamanta a su bébe, en la leche le pasa anticuerpos preformados y ya el bebé se los toma y no necesita hacer nada más que comer para obtener esa inmunidad.
Es la inmunidad que vas obteniendo a lo largo de tu vida
INMUNIDAD ADQUIRIDA O ADAPTATIVA
-Responde más especificamente ante los patógenos.
-Memoria inmunológica que evita una segunda infección.
-Tiempo de respuesta es mayor que el de la innata (horas o días)
-Se adapta para reconocer, eliminar y más tarde recordar al patógeno invasor.
INMUNIDAD ADAPTATIVA O ADQUIRIDA
Tipos de inmunidad adquirida o adaptativa
-Humoral
-Celular
INMUNIDAD ADAPTATIVA HUMORAL
Depende de células plasmáticas, anticuerpo e inmunoglobulinas
INMUNIDAD ADAPTATIVA CELULAR
Necesita de linfocitos T, son capaces de destruir el antigéno.
Notita de inmunidad adaptativa
-Comienzan pocos dias después de la infección inicial.
-SEGUNDA LÍNEA DE DEFESA que elimina los patógenos que evaden las reacciones innatas o presisten a pesar de ellas.
-Reacción inmunitaria adapatativa es la MEMORIA.
-Si el agento patógeno infecta en una segunda ocasión: las c´lulas de memoria permiten que el sistema inmunitario monte un ataque rápido y muy eficas vs el inasor.
Respuesta específica del sistema inmune en la que interviene el reconocimiento de antígenos y la producción de anticuerpos. Mediada por anticuerpos solubles producidos por linfocitos B. El ataque se produce con anticuerpo que inactivan y/o marcan los agentes potebcialemente peligrosos para que sean destruidos.
INMUNIDAD HORMONAL
Mediada por los linfocitos T que atacan directamente a microorganismo intracelulares y sus toxinas. Determinadas células del sistema inmunitario liberan toxinas para matar a los invasores sin la intervención de anticuerpos.
INMUNIDAD CELULAR
Es la inmunidad que adquiere un organismo frente a una enfermedad infecciosa después e haberla padecido. Se debe a la respuesta secundaria al permaner en el medio interno linfocitos B de memoria o los mismo anticuerpos.
INMUNIDAD ACTIVA
¿Quiénes intervienen en la inmunidad activa?
-Fagocitos (macrófagos y neutrófilos)
-Sistema de complemento
-Células NK
-Interleucinas
Según la enfermedad, la inmunidad puede durar activa toda la vida o un intervalo de tiempo.
Esta inmunidad asiste cuando la respuesta inmunitaria activa no es suficiente.
INMUNIDAD PASIVA
Proviene de la sueroterapia, que suministra suero sanguíneo proveniente de un donante inmune.
Inmunidad pasiva